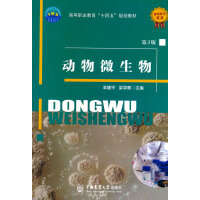
动物微生物

本书内容丰富,全书共13章,全面系统地介绍了兽医统计学的基本原理和方法;特色鲜明,除了介绍生物统计学中常用的几种基本统计方法以外,还介绍了兽医学科中需要使用的统计分析方法,如非参数检验、序贯分析、判别分析和半数致死量等;突出应用性和实践性,每章都安排了大量的兽医统计学案例(例题和复习思考题);内容新颖,大部分例题和复习思考题都引自较新的兽医学科专业文献。本书除作为兽医专业本科生的必修教材外,还可作为兽医科研工作者、兽医临床工作者、兽医教学工作者及兽医学科研究生的参考用书。

《犬科动物讲历史:与人类同行万年》是引进版科普丛书三棱镜的一种,是一部犬类与人类紧密相关的历史。狗为何对我们的历史了如指掌?为什么说狗的故事的总和就是一部人类史的百科全书?以狗狗的眼光来看待整个人类的历史和未来,会有怎样的启示?作者通过12种狗被驯化的过程讲述了狗与人类的关系史。墨西哥无毛犬、澳洲野犬、杂种犬、比利牛斯山地犬、秋田犬、看门犬、猎兔犬等登上讲台,讲述自身的进化和变迁,讲述与人类的相爱相处的前尘往事,生动有趣,发人深思。是一部难得的狗狗口述人类史。

2013年,本书作者之一罗德尼的爱犬萨姆被诊断出患有癌症,于是,罗德尼开始了一场拯救萨姆的行动。当时萨姆5岁,被诊断只能再活6个月。萨姆的困境激励罗德尼开始不懈地寻找新方法来阻止疾病的发展。在拯救萨姆的过程中,罗德尼遇到了世界知 名的兽医贝克尔一位具有20多年经验的积极的宠物健康倡导者。两人很快意识到他们有着相同的目标提高世界各地的狗狗的生存质量。
在过去的3年里,他们环游世界,收集关于狗狗的健康、疾病和寿命的新信息。他们拜访了遗传学家、微生物学家和研究人员,还采访了一些长寿犬的家长,这些狗狗已经活到了20多岁,甚至30多岁。他们发现的事实有可能改变宠物世界,就像它改变了罗德尼爱犬的命运一样。萨姆现在11岁,仍然活蹦乱跳,是罗德尼生活中非常重要的一部分。
罗德尼和贝克尔在全球拥有近500万的追随者,他们决定写作这本书,启动一场养育永生狗的运动,宗旨是让养狗人改变照顾宠物的方式,以改善宠物的健康状况,让它们充满活力,活得更快乐,延长寿命,陪伴我们更久一些。

本书介绍了雷州山羊的起源与生产现状、种质特性、繁殖技术、饲养管理、选育及杂交利用、疫病防控技术、常见病的防治、养殖场的建设及管理、饲草料生产及加工调制、养殖模式及养殖效益分析。针对雷州山羊养殖的难点和经济价值,提出雷州山羊科学的养殖技术和最佳的养殖利用模式;针对不同的养殖类型提出不同的养殖模式并进行效益分析。

本书从介绍肉羊优良品种入手,就肉羊品种的繁殖利用、羊场生态建设、饲料加工调制、福利养殖技术、药物安全使用、生物安全体系建设、常见疾病的防控等方面的內容,介绍了健康养殖生产过程中的新理念、新技术、新方法。